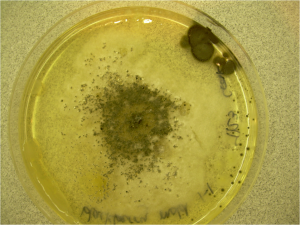
Формула молекулы Acremonium lichenicola | Formula of active ingredient Acremonium lichenicola

Действующее вещество
Acremonium lichenicola
Входит в состав препаратов
Структурная формула

Препараты
Препараты имеющие регистрацию на действующее вещество Acremonium lichenicola в России, составлено gEPA
Препараты+
Препараты имеющие регистрацию на действующее вещество Acremonium lichenicola в Мире, составлено gEPA
Информация от PubChem
На других языках
Английский:
Acremonium lichenicola
Список всех препаратов на действующее вещество Acremonium lichenicola
Таблица составлена при помощи нейросети gEPA.
Информация приведена по состоянию на 19 мая 2026 г..
Фильтр
Подождите пожалуйста, формируется таблица...
| Препарат | Регистрант | Действующее вещество | Стоимость, ₽ | Норма применения | Сроки выхода (ручных) |
|---|
Список препаратов в Мире на действующее вещество Acremonium lichenicola
Таблица составлена при помощи нейросети gEPA.
Фильтр
Подождите пожалуйста, формируется таблица...
| Препарат | Регистрант | Тип | Страна | Мин. норма | Макс. норма | Кратность обработок |
|---|
Справочники у вас в кармане! Больше не нужно листать десятки сайтов.
Устали искать актуальную информацию по препаратам? GOLD решает это!
Наша нейросеть gEPA сделала для вас: собрала информацию, проверила и структурировала данные в удобные справочники по пестицидам, удобрениям и семенам.
Можно подобрать по названию, культуре, действующему веществу или вредителю — всегда быстро и точно.
Всё работает даже без интернета и постоянно обновляется. Сохраняйте данные из справочников прямо в свои заметки и дополняйте своими исследованиями!
Оформите GOLD и получите доступ к базе знаний 24/7.
Устали искать актуальную информацию по препаратам? GOLD решает это!
Наша нейросеть gEPA сделала для вас: собрала информацию, проверила и структурировала данные в удобные справочники по пестицидам, удобрениям и семенам.
Можно подобрать по названию, культуре, действующему веществу или вредителю — всегда быстро и точно.
Всё работает даже без интернета и постоянно обновляется. Сохраняйте данные из справочников прямо в свои заметки и дополняйте своими исследованиями!
Оформите GOLD и получите доступ к базе знаний 24/7.
